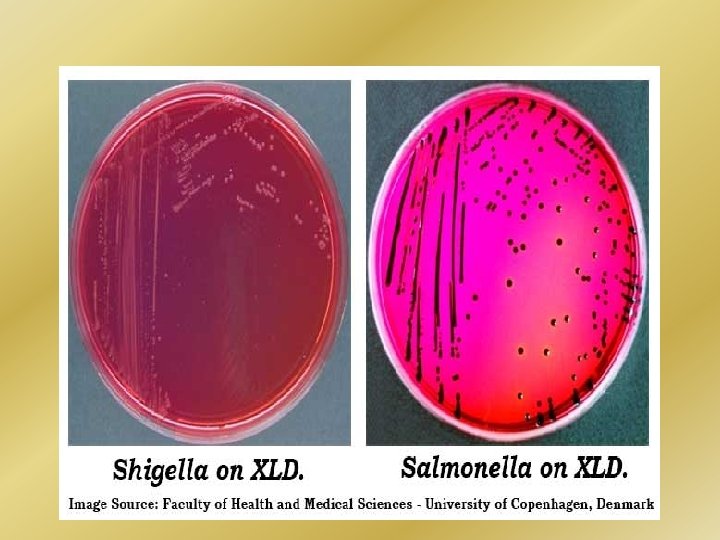

SALMONELLA SHIGELLA Prof Ali Somily Prof Hanan Habib

SALMONELLA & SHIGELLA Prof. Ali Somily & Prof. Hanan Habib Department of Pathology College of medicine

Objectives 1 - Develop an algorithm using biochemical tests to identify and classify Salmonella and Shigella 2 - Describe the antigenic structures and virulence factors of Salmonella and Shigella 3 - Compare the pathogenesis of various species of Salmonella and Shigella 4 -Describe the clinical features and risk factors for the infection with the two organisms 5 - Describe the general concepts for the management of gastroenteritis caused by both organisms.

Salmonella

Salmonella Ø Ø Ø Gram negative , motile , facultative anaerobic bacilli Non lactose fermenting colonies highest during the rainy season in tropical climates and during the warmer months in temperate climates.

VIRULENCE FACTORS � � Fimbria - Adherence Endocytosis �SPI 1 �TLR T 3 SS � Replication in microphage � Enterotoxin

Histopathology

Classification Two species of Salmonella : -Has two(six species s. enterica Ø S. enterica subspecies I, III, IV, (six V, VI) subspecies I, III, IV, V, VI) Ø S. borgori (rare) s. borgori (rare) Found in cold blooded animal, birds, rodents, -Cold animal, birds, rodents, turtles, blooded snakes and fish turtles, snake and fish

SALMONELLA SPECIES AND SUBSPECIES NO. OF SEROTYPES WITHIN SUBSPECIES USUAL HABITAT S. enterica subsp. enterica (I) 1504 Warm-blooded animals S. enterica subsp. salmae(II) 502 Cold-blooded animals and the environment* S. enterica subsp. arizonae (IIIa) 95 Cold-blooded animals and the environment* S. enterica subsp. diarizonae (IIIb) 333 Cold-blooded animals and the environment* S. enterica subsp. houtenae (IV) 72 Cold-blooded animals and the environment* S. enterica subsp. indica(VI) 13 Cold-blooded animals and the environment* S. bongori (V) 22 Cold-blooded animals and the environment* Total 2541

Antigenic structures � � � O. Somatic antigen H. Flagellar antigen K. Capsular antigen

VI in Salmonella serotype typhi (virulence heat-labile capsular homopolymer of N-acetylgalactosamino-uronic acid) vs phagocytosis � O Antigen (Heat – stable) is lipopolysaccharide in the outer membrane A, B, C 1, C 2, D, E � H-antigen (Heat labile) �

Clinical diseases � Acute gastroenteritis � Typhoid fever � Nontyphoidal bacteremia � Carrier state following Salmonella infection

Source Water, food and milk contaminated with human or animal excreta. v S. typhi and S. paratyphi : the source is human. v

Salmonella gastroenteritis v v v v Food poisoning through contaminated food S. enterica subsp. enterica the common cause Source : poultry, milk, egg & egg products and handling pets Infective dose: 106 bacteria Incubation period : 8 – 36 hrs. fever, chills, watery diarrhea and abdominal pain. Self limiting. In sickle cell , hemolytic disorders , ulcerative colitis, elderly or very young patients; the infection may be very severe. Patients at high risk for dissemination and antimicrobial therapy is indicated.

Enteric fever (Typhoid fever) Ø Ø Ø Ø Prolonged fever Bacteremia Involvement of the reticulo endothelial system (liver, spleen, intestines and mesentery) Dissemination to multiple organs Ingestion of contaminated food by infected or carrier individual Caused by Salmonella serotype typhi or S. paratyphi A, B and C (less severe) Common in tropical , subtropical countries, and travelers (sewage , poor sanitation). IP : 9 – 14 days.

First week: fever, malaise, anorexia, myalgia and a continuous dull frontal headache then, v Patient develops constipation v Mesenteric lymph node blood stream liver, spleen and bone marrow v Engulfment of Salmonella by mononuclear phagocytes. v Bacteria released into the blood stream again and can lead to high fever. Blood culture is positive.

2 nd and 3 rd week v Sustained fever & prolonged bacteremia. v Invade gallbladder and Payer's patches v Rose spots 2 nd week of fever v Billiary tract GIT v Organism isolated from stool. �

Management & Antibiotics Enteric fever: � Ceftriaxone � Ciprofloxacin � Trimelhoprim – Sulfamethoxazole � Ampicillin � Azithromycin or Ceftriaxone for patients from India and SE Asia due to strains resistant to Ciprofloxacin can be used for patients from other areas. Salmonella gastroenteritis: � Uncomplicated cases require fluid and electrolyte replacement only.

COMPLICATIONS � Necrotizing cholecystitis � Bowel hemorrhage and perforation � Pneumonia and thrombophlebitis � Meningitis, osteomyelitis, endocarditis and abscesses.

Shigella

�Shigella is non lactose fermenting Gram negative bacteria. �Cause bacillary dysentery ( blood, mucus and pus in the stool)

ANTIGENIC STRUCTURES Shigella has 4 species and 4 major O antigen groups: � All have O antigens , some serotypes has K antigen( heat labile removed by boiling) � Shigella are non motile , lack H antigen �


CLINICAL INFECTION � � � S. sonnei (group D 1) most predominant in USA ( fever, watery diarrhea) S. flexneri (group B 15) 2 nd most common Young adult ( man who have sex with man) S. dysenteriae (group A 6 )and S. boydii (group C 20) are most common isolates in developing countries S. dysenteriae type 1 associated with morbidity and mortality. Human is the only reservoir

Ø Ø Ø Person to person through fecal –oral route. Flies, fingers ( have a role in spread). Food and water. Young children in daycare, people in crowded area and anal oral sex in developed countries. Low infective dose < 200 bacilli Penetrate epithelial cells , leads to local inflammation, shedding of intestinal lining and ulcer formation.

SYMPTOMS � � � High fever, chill, abdominal cramp and pain accompanied by tenesmus , bloody stool with mucus & leukocytes. Incubation period : 24 - 48 hrs Can lead to rectal prolapsed in children Complications: ileus, obstruction dilatation and toxic mega colon Bacteremia in 4 % of severely ill patient

DYSENTRY STOOL

Laboratory diagnosis of Salmonella & Shigella from stool -Both are Gram negative bacilli -Culture on selective media ( Salmonella produce black colonies due to H 2 S) -Biochemical tests -Motility test -Serology for serotypes.

BIOCHEMICAL TESTS


Diagnosis � � 1. Stool culture on selective selenite enrichment broth media MAC, SS and XLD, HEA BS Sero-grouping based on O and H antigen Sereny test

TREATMENT Antibiotic s used to reduce duration of illness ampicillin , oral TMP-SMX or IV ceftriaxone and ciprofloxacin or doxycycline.

References Ryan, Kenneth J. . Sherris Medical Microbiology, Seventh Edition. Mc. Graw-Hill Education. - Intestinal flora, part of chapter 1 - Enteric infections and food poisoning, part of the chapter on Infectious Diseases. -Typhoid fever - Dysentry
- Slides: 33